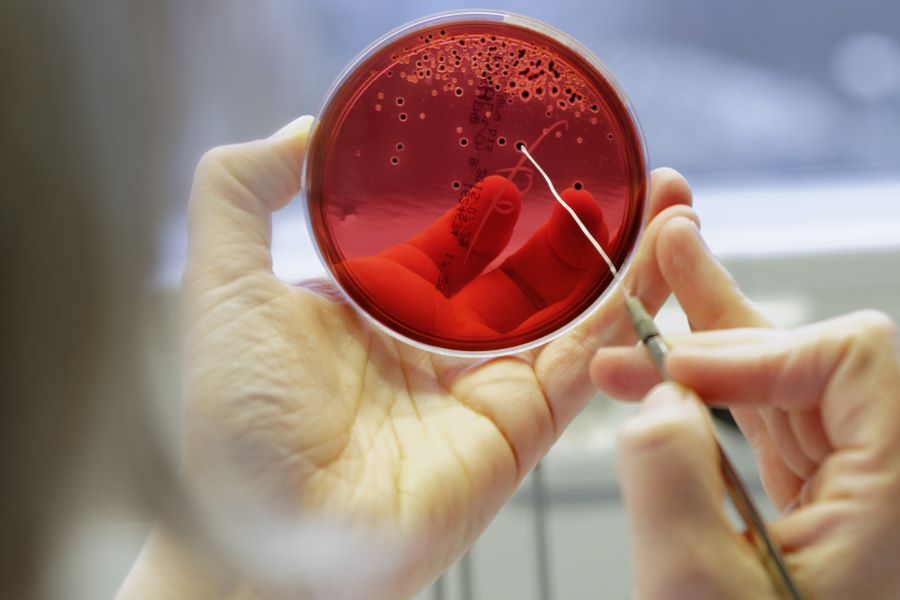

Bakterien im Blut können lebensgefährlich sein. Die HELP-App der Medizininformatik-Initiative lotst Ärztinnen und Ärzte durch die ersten Behandlungsschritte. Der digitale Helfer wurde in einer Studie getestet – und zeigt das Potenzial vernetzter Gesundheitsdaten.
Mikrobiologische Auswertung einer Blutkultur im Universitätsklinikum Jena.
Schroll/Universitätsklinikum Jena
Staphylokokken leben als unauffällige Mitbewohner auf unserer Haut oder in der Nase, doch können die Bakterien gefährliche Infektionen verursachen, wenn sie in den Blutstrom gelangen. Besonders gefürchtet ist Staphylococcus aureus, ein weitverbreiteter Erreger, mit dem sich Patientinnen und Patienten beispielsweise während eines Klinikaufenthalts infizieren können. Eine durch S. aureus ausgelöste Sepsis kann für Betroffene lebensbedrohlich sein und muss schnell und gezielt behandelt werden.
Es gibt aber auch gänzlich harmlose Staphylokokken-Arten. Sie werden oft in Blutproben als nachträgliche Verunreinigung gefunden, ohne dass eine Infektion vorliegt. Eine dennoch gestartete Behandlung der Betroffenen mit Antibiotika ist in diesem Fall unnötig belastend. Zudem steigt so die Wahrscheinlichkeit, dass Erreger Resistenzen entwickeln.
Was also tun bei einem positiven Staphylokokken-Nachweis im Klinikalltag? Für eine angemessene Antibiotikabehandlung ziehen Ärztinnen und Ärzte möglichst Fachleute für Infektionsmedizin zu Rate. In vielen Kliniken fehlt diese Expertise jedoch, insbesondere in kleineren Krankenhäusern.
Digitaler Leitfaden für die Kitteltasche

Bei einem positiven Staphylokokken-Befund lotst die HELP-App die Ärztinnen und Ärzte durch die ersten Behandlungsschritte.
privat
Um diese Versorgungslücke zu schließen, entwickelte ein Team des SMITH-Konsortiums der Medizininformatik-Initiative (MII) einen digitalen Entscheidungshelfer. Dazu erarbeitete das Team am Universitätsklinikum Jena gemeinsam mit Partnern aus der Infektiologie und der medizinischen Mikrobiologie aus den Universitätskliniken Aachen, Essen, Halle, und Leipzig das HELP-Manual: eine App in Form eines elektronischen Handbuchs, die Klinikerinnen und Klinikern eine einfache Entscheidungsunterstützung bietet.
„Auf dem Smartphone ist die HELP-App ein ansprechend aufbereiteter Leitfaden für die Kitteltasche“, sagt Professor Dr. André Scherag, der das Institut für Medizinische Statistik, Informatik und Datenwissenschaften am Universitätsklinikum in Jena leitet. Verknüpft mit dem mikrobiologischen Befund begleitet die Web-App leitliniengerecht durch erste diagnostische und therapeutische Schritte, wenn ein Verdacht auf Staphylokokken-Infektionen besteht.
Das Projekt wurde vom Bundesministerium für Forschung, Technologie und Raumfahrt (BMFTR) gefördert. Im Rahmen einer Studie wurde die HELP-App zudem in der klinischen Praxis erprobt. „Das war zugleich ein Testlauf für die vernetzten Datenintegrationszentren, die im Rahmen der Medizininformatik-Initiative an den Universitätskliniken etabliert wurden“, so Scherag, der auch Erster Sprecher von SMITH ist.
Datenintegrationszentren der Medizininformatik-Initiative
Die vom Bundesforschungsministerium seit 2016 mit mehr als 480 Millionen Euro geförderte Medizininformatik-Initiative (MII) schafft Grundlagen für eine datenbasierte Medizin in Deutschland. Die an allen deutschen Universitätskliniken und weiteren Standorten errichteten Datenintegrationszentren bilden wichtige Knotenpunkte der bundesweiten Forschungsdateninfrastruktur. Die Datenintegrationszentren können Behandlungsdaten aus der Patientenversorgung, zum Beispiel zu Laborbefunden und Therapien, in eine standardisierte Form bringen und für Forschungsprojekte nutzbar machen. Vorgaben für den Datenschutz und die Datensicherheit werden dabei streng beachtet.
Insgesamt wurden Daten von 5.056 Patientinnen und Patienten auf 134 Intensiv- und Normalstationen an den beteiligten fünf Unikliniken in die Studie eingeschlossen. Das Studienteam führte die Nutzung des HELP-Manuals schrittweise auf den Stationen ein und verglich die Behandlungsergebnisse mit und ohne Manual.
Insgesamt erwies sich das elektronische Handbuch als sicher. „Im Ergebnis war die Sterblichkeit auf Stationen mit HELP-Manual geringfügig niedriger als auf Stationen ohne die App“, sagt Julia Palm, die die Ergebnisse der Studie im Rahmen ihrer Doktorarbeit ausgewertet hat. Für die Langzeitsterblichkeit und das Wiederauftreten von Infektionen sowie für den Antibiotikaeinsatz ließ sich kein Unterschied nachweisen.
In einer Umfrage wurden 40 Ärztinnen und Ärzten auf den teilnehmenden Stationen zur Nutzerfreundlichkeit des HELP-Manuals befragt. Etwa die Hälfte gab an, das HELP-Manual genutzt zu haben. Die Mehrheit davon bewertete die App als sehr benutzerfreundlich.
Mehrwert der Datenintegrationszentren aufgezeigt
Die App wurde als elektronisches Handbuch so gestaltet, dass sie niedrigschwellig und unkompliziert in den Klinikalltag integriert werden kann. Mit der Veröffentlichung der Studie haben die Forschenden des SMITH-Konsortiums zudem den Quellcode der Web-App veröffentlicht. Interessierte können nun darauf aufbauen, um das Tool als innovatives Produkt für den Markt weiterzuentwickeln.

Professor Dr. André Scherag
Gildemeister Fotografie/SUK
„Die Ergebnisse unserer Studie legen nahe, dass das HELP-Manual besonders in kleineren Krankenhäusern ohne infektiologische Expertise eine wertvolle Unterstützung bieten könnte“, sagt Scherag. Der Nutzen solcher digitalen Systeme hänge aber davon ab, wie gut sie in die bestehenden IT-Strukturen eines Krankenhauses integriert werden könnten.
In dieser Hinsicht hatten die Forschenden mit manchen Widrigkeiten zu kämpfen, auch weil die Studie teilweise während der Corona-Pandemie durchgeführt wurde. „Umso wichtiger ist der Nachweis, dass die standortübergreifende Harmonisierung und Auswertung der Daten über die Datenintegrationszentren funktioniert und sich diese Infrastruktur auch für komplexere, versorgungsnahe Studien nutzen lässt“, so Scherag.
Originalpublikation:
Palm, J., Alaid, S., Ammon, D., et al. (2025). Leveraging electronic medical records to evaluate a computerized decision support system for staphylococcus bacteremia. npj Digital Medicine. 8, 180. DOI: 10.1038/s41746-025-01569-3
Wissenschaftlicher Ansprechpartner:
Prof. Dr. André Scherag
Institut für Medizinische Statistik, Informatik und Datenwissenschaften
Universitätsklinikum Jena
Bachstraße 18
07743 Jena
Andre.Scherag@med.uni-jena.de